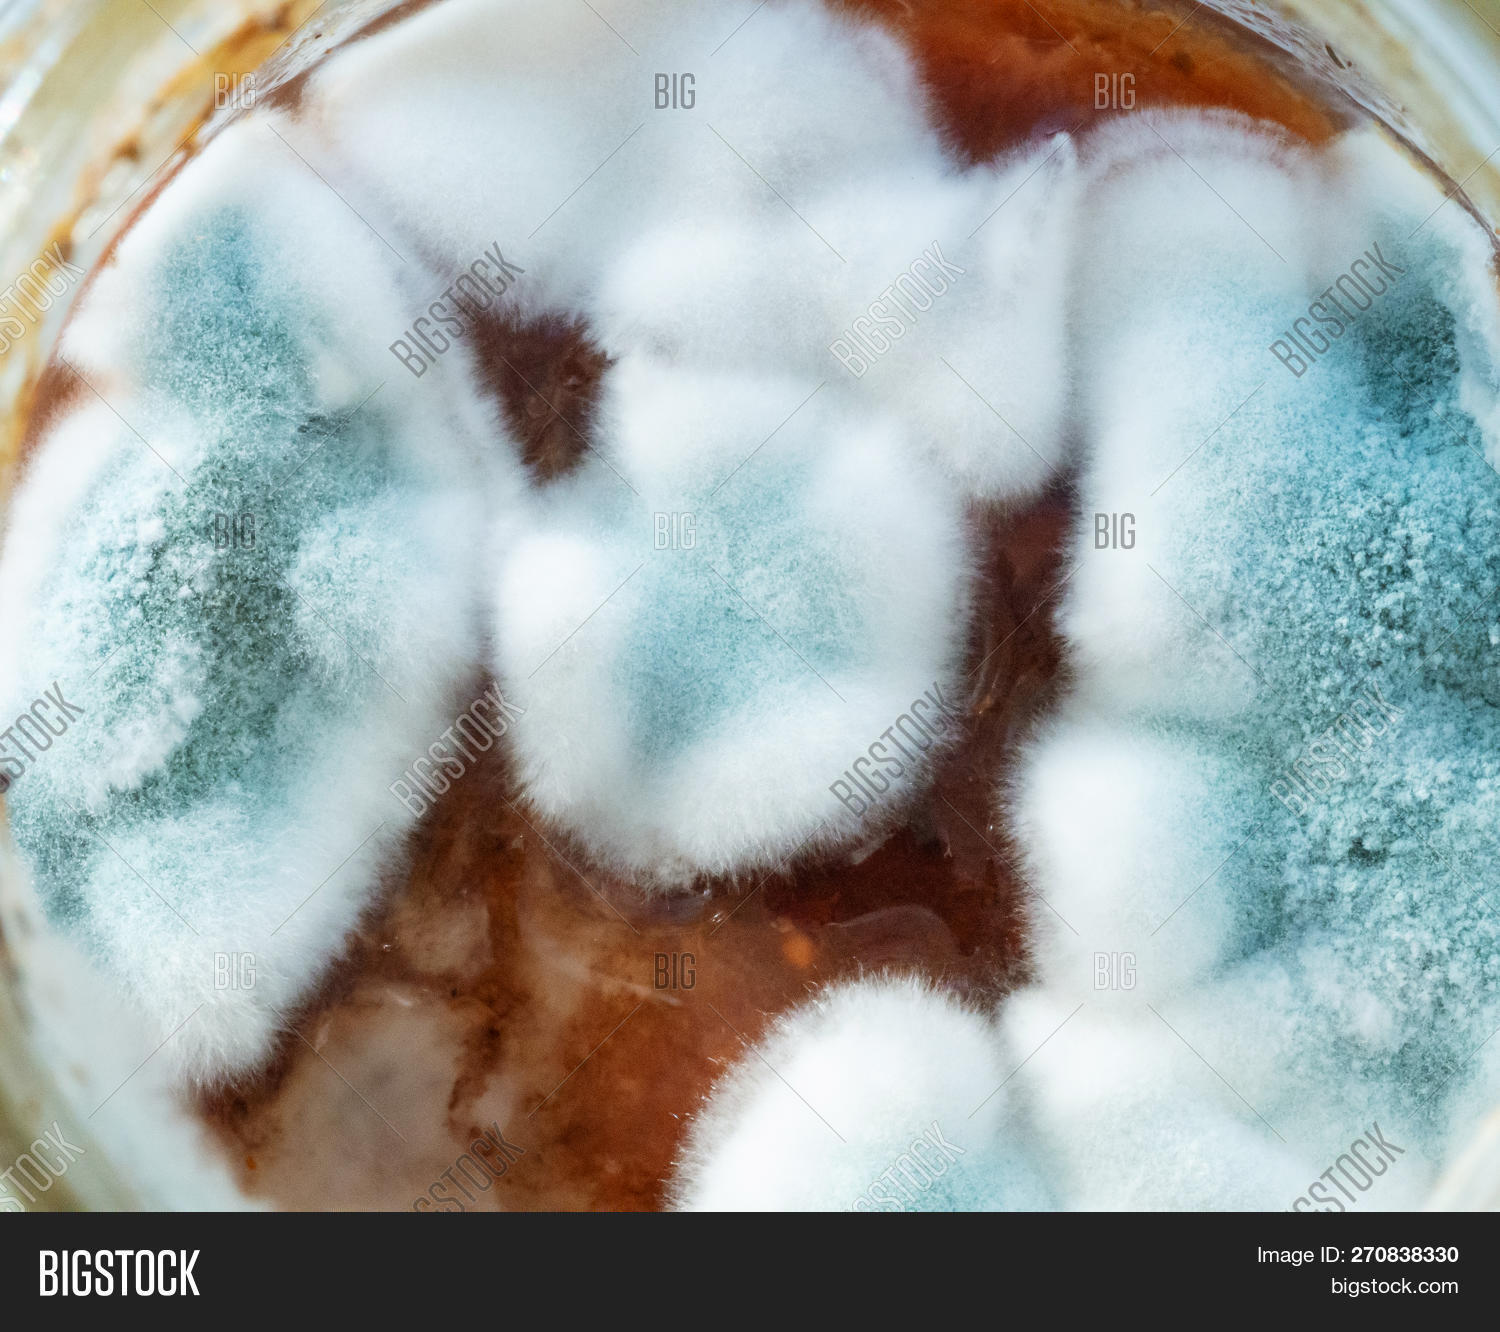

Почему варенье покрывается плесенью
Ковры carving
Ярославский педагогический университет отзывы
Школа 40 телефон директора
Серая птичка по английски и по китайски
Aatrox league
Букеты из своего сада
Что по английскому проходите
Что значит стать личностью
Песни фабиан видео
Забайкальские первоцветы
Aegon ii
Реши уравнения х 23 8
Не заводится бензопила свеча сухая
Почему варенье покрывается плесенью 106 фото